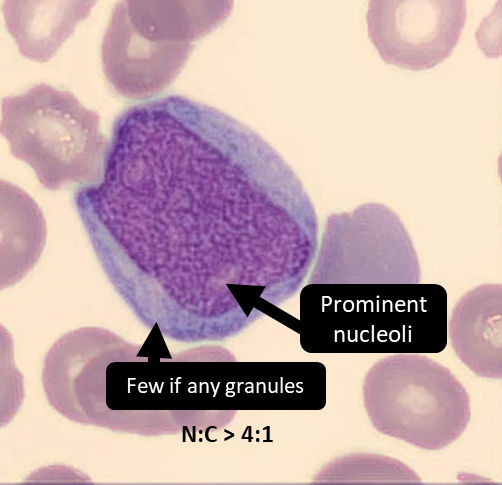
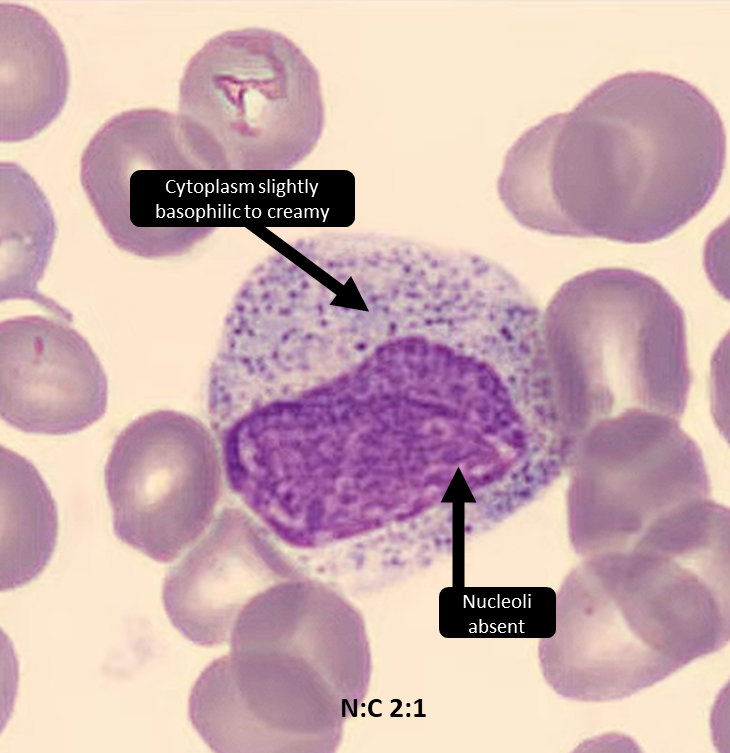
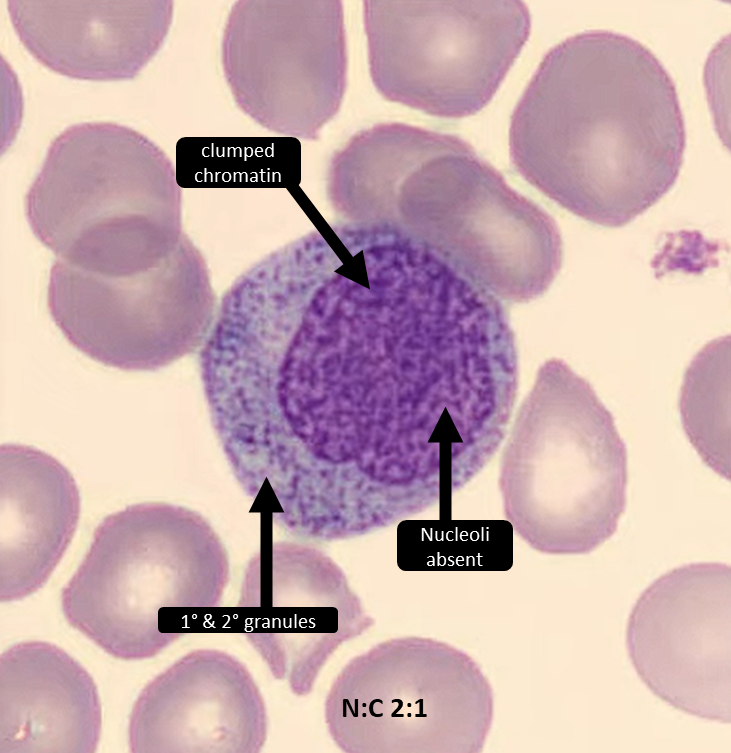
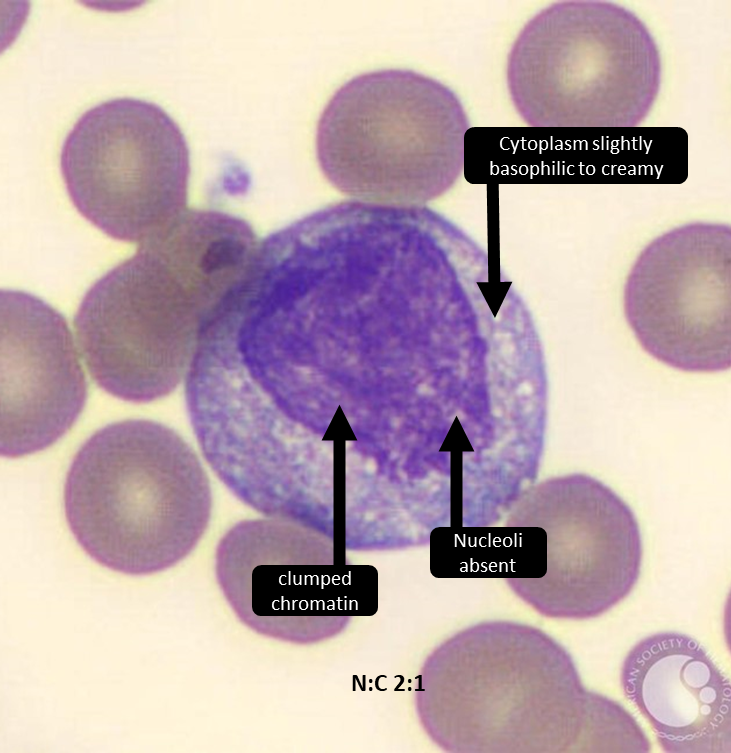
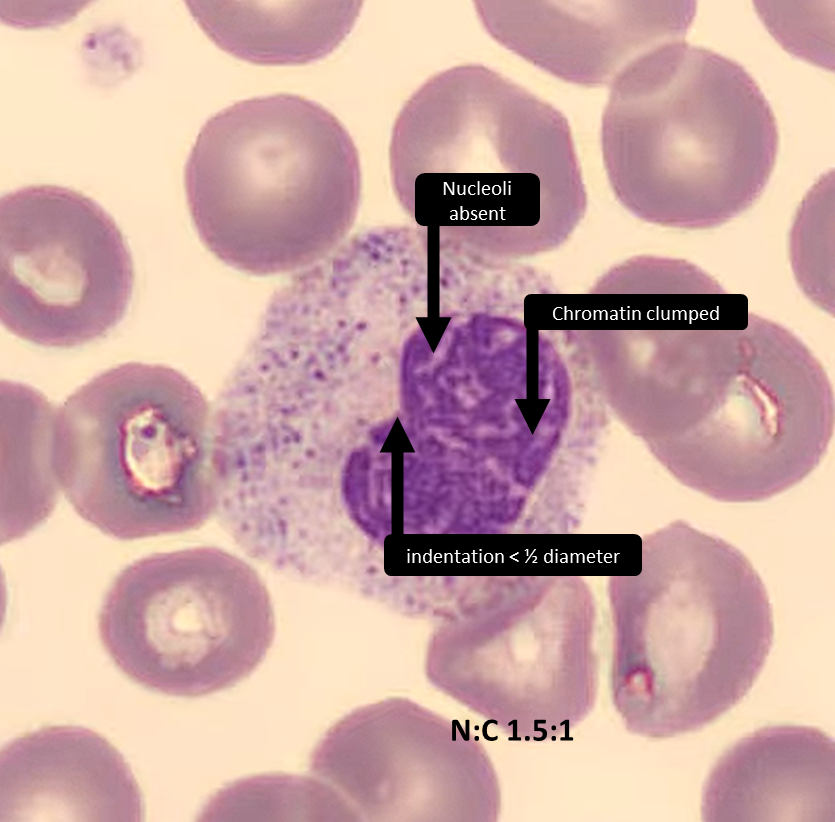
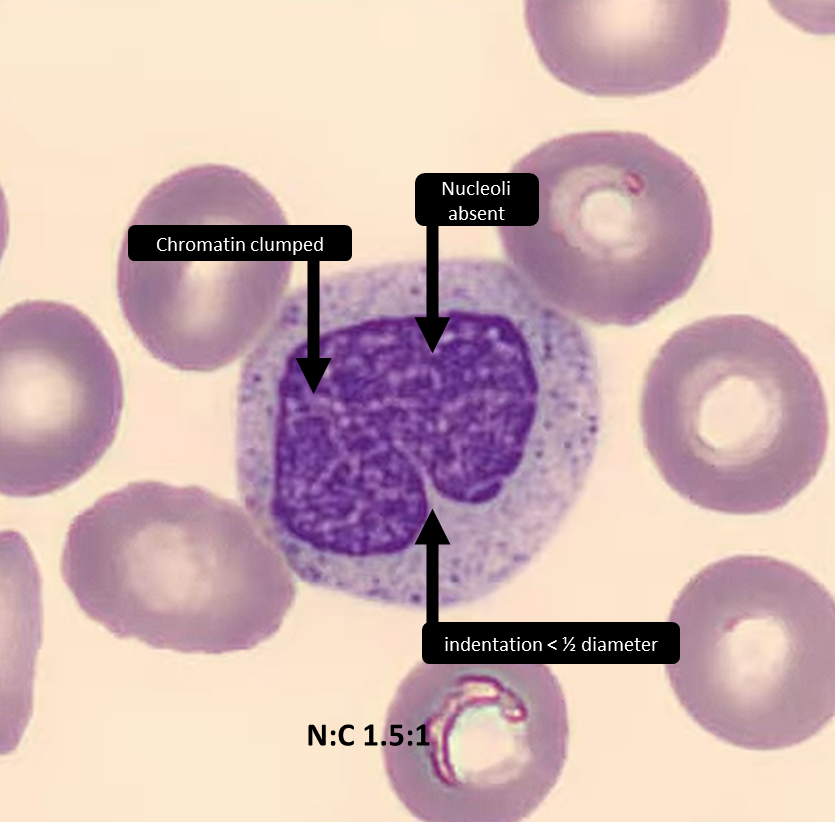

3 cells, can you get them all right!?
What is cell #1?
A) Myeloblast
B) Myelocyte
C) Metamyelocyte
D) Band form
#HemePath #Hematology #pathology #PathTwitter x.com
What is cell #1?
A) Myeloblast
B) Myelocyte
C) Metamyelocyte
D) Band form
#HemePath #Hematology #pathology #PathTwitter x.com
What is cell #1?
#1
Few if any granules
Fine (immature) chromatin
Prominent nucleoli
N:C > 4:1
#HemePath #Hematology #pathology #PathTwitter
✅Myeloblast x.com
Few if any granules
Fine (immature) chromatin
Prominent nucleoli
N:C > 4:1
#HemePath #Hematology #pathology #PathTwitter
✅Myeloblast x.com
What is cell #2?
#2
Cytoplasm slightly basophilic to cream-colored
Nucleoli are absent
Eccentric nucleus with clumped (mature) chromatin
N:C 2:1
#HemePath #Hematology #pathology #PathTwitter
✅Myelocyte x.com
Cytoplasm slightly basophilic to cream-colored
Nucleoli are absent
Eccentric nucleus with clumped (mature) chromatin
N:C 2:1
#HemePath #Hematology #pathology #PathTwitter
✅Myelocyte x.com
What is cell #3?
#3
Chromatin clumped
Kidney bean nucleus (indentation < ½ diameter)
Nucleoli absent
More cytoplasm with only 2° granules
N:C 1.5:1
#HemePath #Hematology #pathology #PathTwitter
✅Metamyelocyte x.com
Chromatin clumped
Kidney bean nucleus (indentation < ½ diameter)
Nucleoli absent
More cytoplasm with only 2° granules
N:C 1.5:1
#HemePath #Hematology #pathology #PathTwitter
✅Metamyelocyte x.com
Master myeloid maturation with this newer module I made!↘️↘️↘️↘️
classmarker.com
#HemePath #Hematology #pathology #PathTwitter x.com
classmarker.com
#HemePath #Hematology #pathology #PathTwitter x.com
جاري تحميل الاقتراحات...